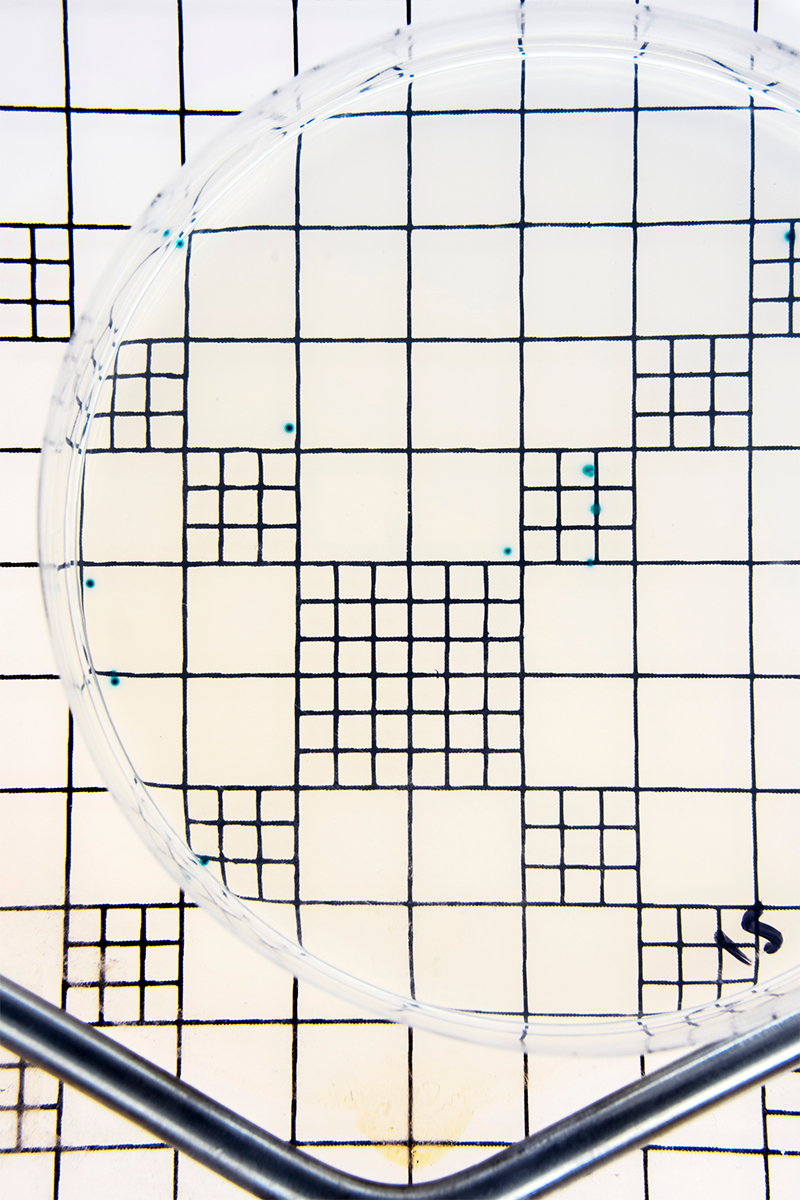

POISON STREAM - The Sarno is the most polluted river in Europe. Running a few kilometers north of the archaeological site of Pompeii and flowing into the Gulf of Naples, it crosses a vast area with its poisonous miasmas and dark, muddy waters intoxicating the lives and health of two and a half million inhabitants, who have suffered a surge in cases of cancer. A century of political immobility, combined with the interference of the Camorra, has led to the inability to find a solution; but now a series of new projects to save the river have just been launched.